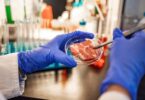

As autoridades chinesas detetaram, nos últimos meses, vestígios do novo coronavírus (SARS-CoV-2) em várias embalagens de produtos refrigerados, incluindo carne brasileira e camarão equatoriano. Em Portugal, a Direção-Geral de Alimentação e Veterinária (DGAV) garante que é totalmente seguro consumir produtos alimentares importados.
“Todos os produtos importados dentro da União Europeia (UE) só podem ser importados através dos chamados postos de controlo de fronteira”, onde há médicos veterinários “em permanência”, garante a diretora-geral da DGAV, Susana Pombo, em declarações à TSF.
Nestes centros é verificado “se os países que estão a exportar para a UE são países autorizados” e se “os estabelecimentos de onde vêm esses géneros alimentícios estão também autorizados”.
A responsável frisa que a totalidade dos produtos comercializados no espaço comunitário é “inspecionada a 100%” e, por isso, considerada “segura”.

Apesar destes mecanismos de inspeção, Susana Pombo alerta que o controlo sanitário dos alimentos depende bastante das empresas do setor e, por isso, “o controlo e os procedimentos que existem” nas mesmas são “muito importantes”.
“Daí terem formações muito rigorosas na parte da higiene”, para que existam “garantias de segurança” na manipulação do produto e se previna a contaminação.
Até agora, não foi detetado nenhum produto alimentar com vestígios do novo coronavírus em Portugal.